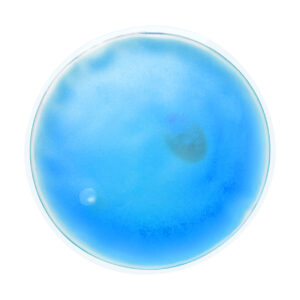

Relief melegítő tasak
324 Ft
* Az ár a 27% ÁFA-t még nem tartalmazza. A kosarat megtekintve már látható. itt. A szállítási információkat itt lehet átnézni: itt.
Termékleírás
Átlátszó, újrahasználható melegítő tasak színes géllel.
Termék jellemzők
- Egyedi TermékkódAP781012
- Anyag 1Műanyag
- Méretø100×10 mm
Gyűjtőcsomagolás adatok
- Kis gyüjtőcsomagban összesen (db)50
- Kis gyűjtőcsomag típusabelső karton
- Nagy gyüjtőcsomagban összesen (db):200
- Nagy gyüjtőcsomag típusakarton
- Csomag hossza (cm)44.5
- Csomag szélessége (cm)31.5
- Csomag magassága (cm)16.5
- Csomagtérfogat (m³)0.023128875
- Csomag nettó súlya (kg)12.6
- Csomag bruttó súlya (kg)13.6
Készlet információ
- Készlet állapota:instock
Termék cimkék
Delivery & Returns
Lorem ipsum dolor sit amet, consectetur adipiscing elit, sed do eiusmod tempor incididunt ut labore et dolore magna aliqua. Sit amet mattis vulputate enim nulla aliquet.
Készlet információk
| Fotó | Termék / Méret | Központi (1-2 napon belül elérhető) | Központi Beérkező | Külső (3-4 napon belül elérhető) | Külső Beérkező |
|---|---|---|---|---|---|
| kék AP781012-06 | 5790 | 20000 db 📅 2026-03-20 | 0 db | 0 db |
 | zöld AP781012-07 | 0 db | 18567 db 📅 2026-03-20 | 0 db | 0 db |
 | pink AP781012-25 | 35563 | 5000 db 📅 2026-03-20 | 0 db | 0 db |
 | fehér AP781012-01 | 6777 | 50000 db 📅 2026-07-08 | 0 db | 0 db |
 | sárga AP781012-02 | 5 | 10000 db 📅 2026-07-08 5000 db 📅 2026-03-20 | 0 db | 0 db |
 | piros AP781012-05 | 0 db | 19900 db 📅 2026-03-20 | 0 db | 0 db |
You May Also Like


Stressul stresszlabda
457 Ft

Furgone Plus stresszlabda
849 Ft

Primero stresszlabda
429 Ft

Relixa Mini stresszlabda
234 Ft

Landline stresszlabda
591 Ft

Eurochill stresszlabda
477 Ft






